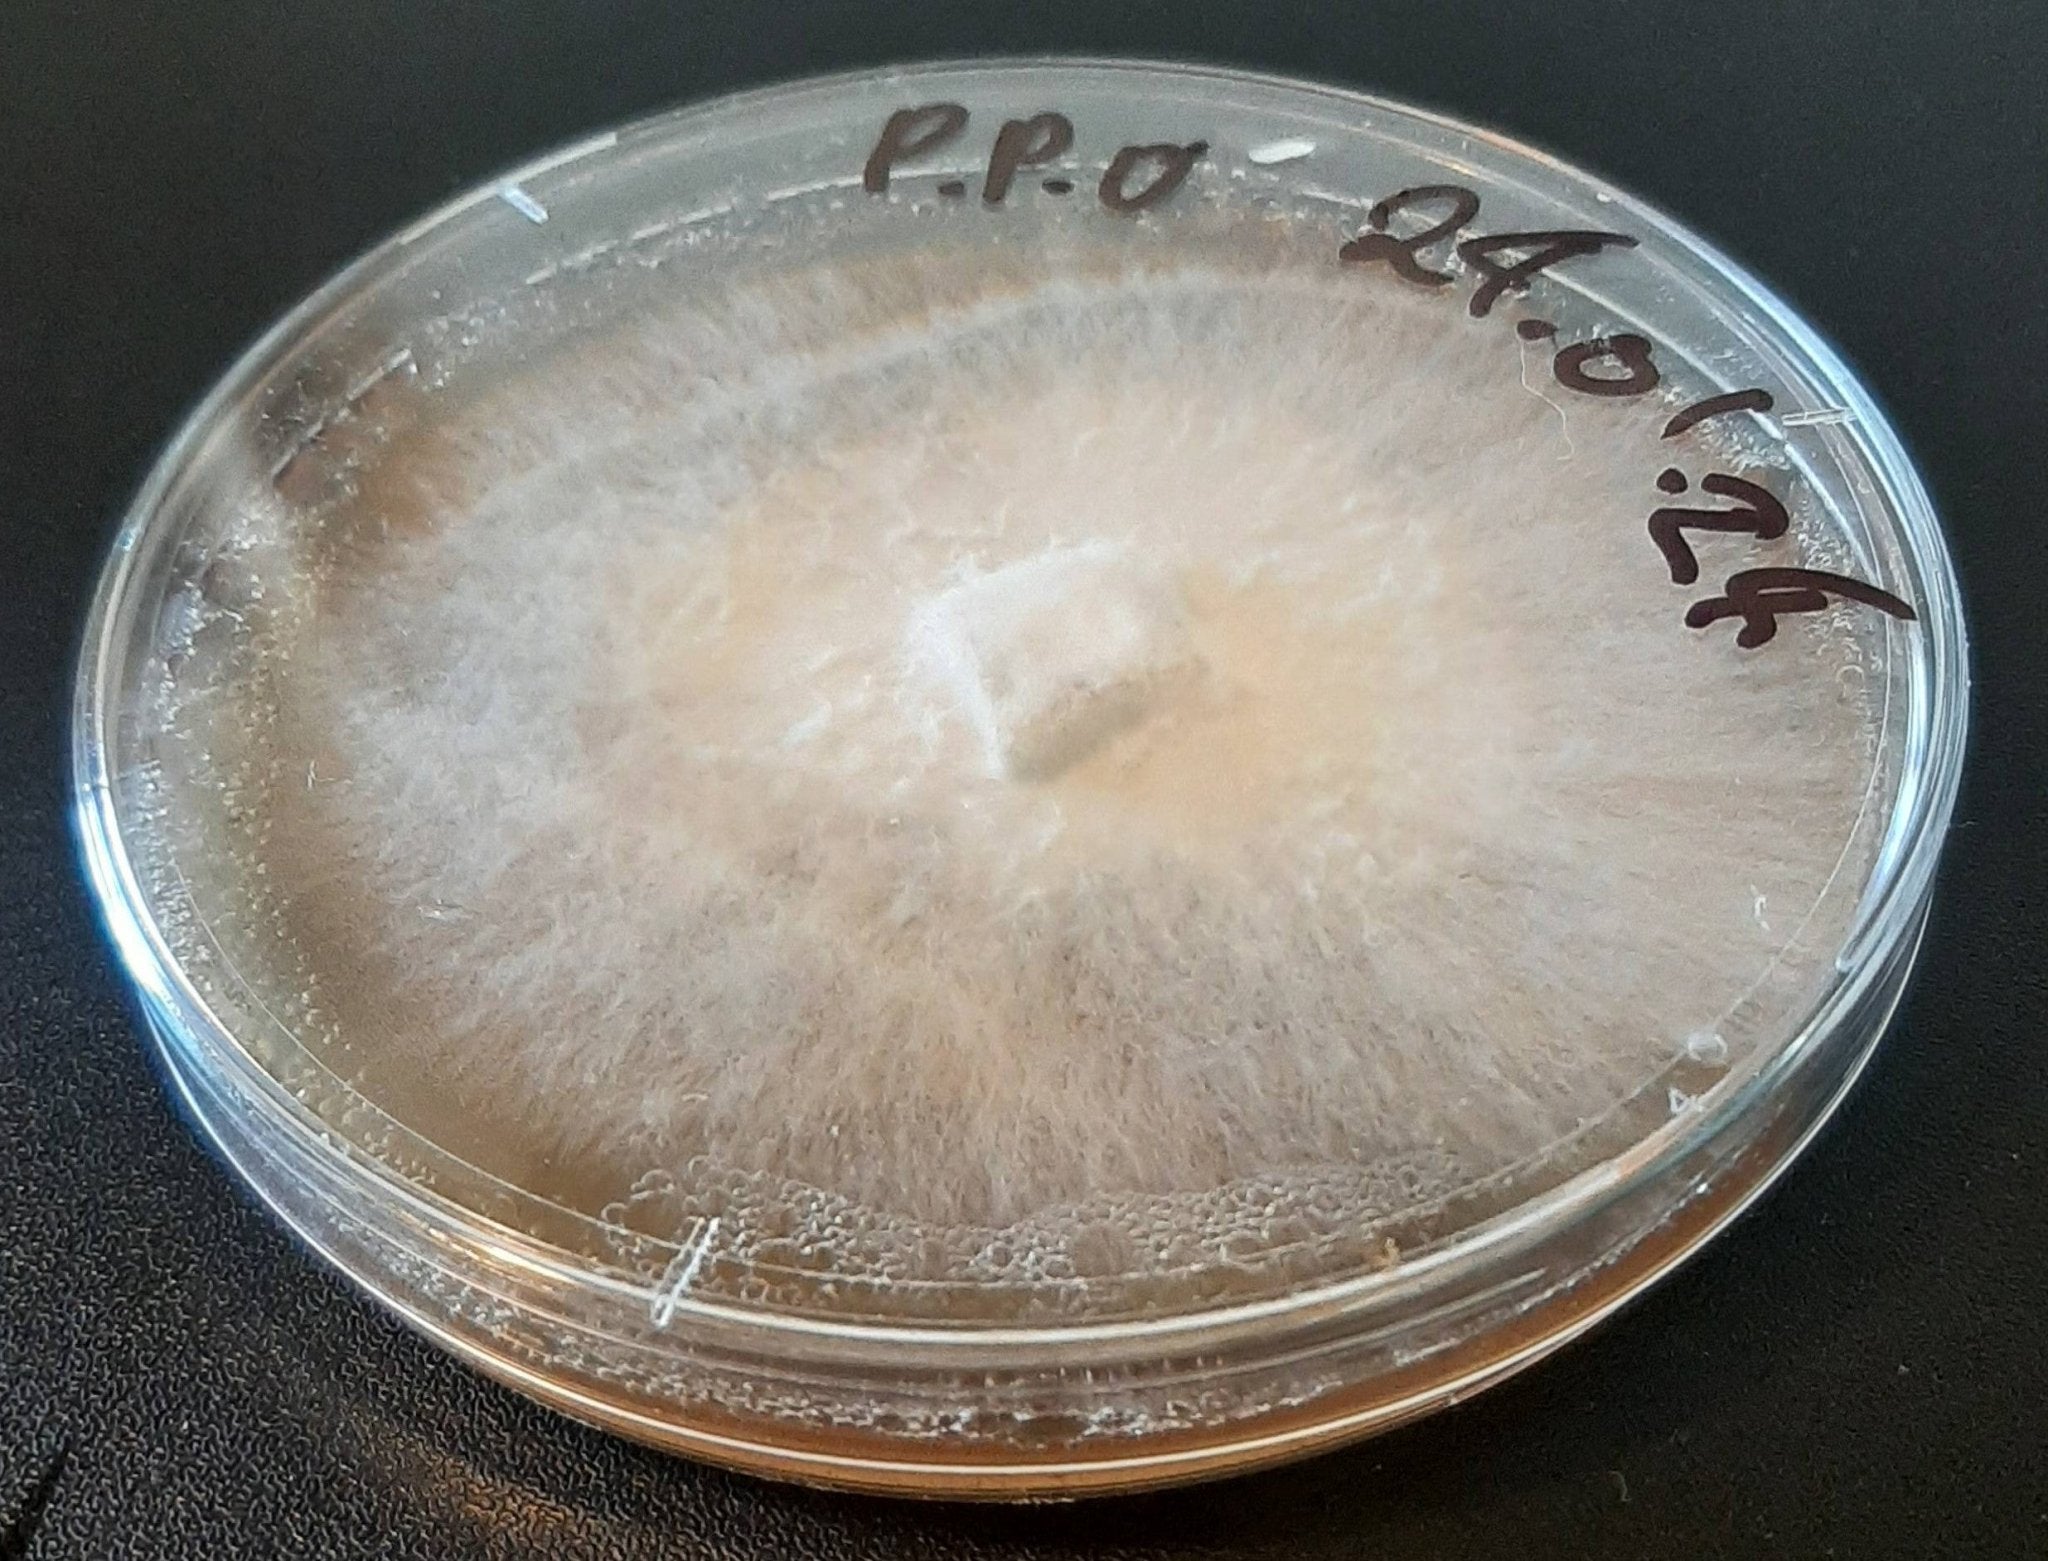
General information for new growers â The Mushroom Smith

product description:

General information for new growers â The Mushroom Smith
General information for new growers â The Mushroom Smith
Brexit 'Will Mean Death of Farming Industry' stan smith mushroom Switzerland, EU to Negotiate on Immigration Limits stan smith mushroom German President to Step Down, a Potential Problem for Merkel stan smith mushroom British Press Full Of ‘Gossip Fiends’ And ‘Barbarians’ Says Chinese Paper stan smith mushroom
stan smith mushroom Gold White Black Red Blue Beige Grey Price Rose Orange Purple Green Yellow Cyan Bordeaux pink Indigo Brown Silver
Product reviews:




Sean
2025-10-23 iphone 7 Plus
adidas unveils the stan smith mylo made with mushroom-grown leather stan smith mushroom
stan smith mushroom

Hayden
2025-10-31 iphone 7
Tennis icon Stan Smith and director Danny Lee discuss new documentary stan smith mushroom
stan smith mushroom

Larry
2025-10-28 iphone 11 Pro
Buy Stan Smith Freizeit 'Redwood' - ID1385 | GOAT stan smith mushroom
stan smith mushroom

Mike
2025-10-26 iphone 11 Pro Max
Stan Smith | American Dad Wikia | FANDOM powered by Wikia stan smith mushroom
stan smith mushroom

Customer Reviews:
| Full Name: | |
| Title: | |
| Description: | |
| Rating Value: | |
| Time: | 2025-11-01 06:44:35 |
Customers who viewed this item also viewed:































